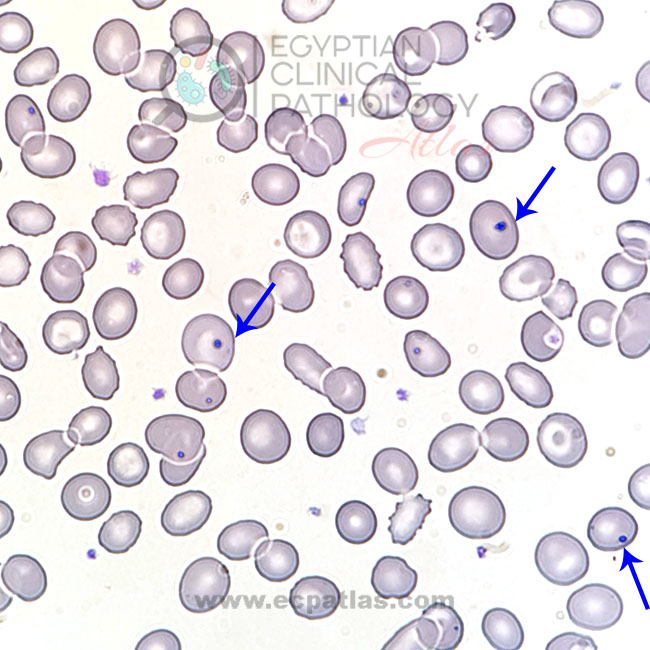

ECPAtlas @ECPAtlas
Official account for Egyptian Clinical Pathology Atlas. https://t.co/AWtbdzcnsC https://t.co/kDOPylysbT ecpatlas.com Joined April 2020-
Tweets169
-
Followers158
-
Following1
-
Likes10
Trends for United States
183 B posts
11,7 B posts
55,7 B posts
1.250 posts
1.881 posts
10,9 B posts
35,3 B posts
1.713 posts
13,4 B posts
131 B posts
43,7 B posts
4.672 posts
11,5 B posts
32,1 B posts
22,9 B posts
1.072 posts
7.673 posts